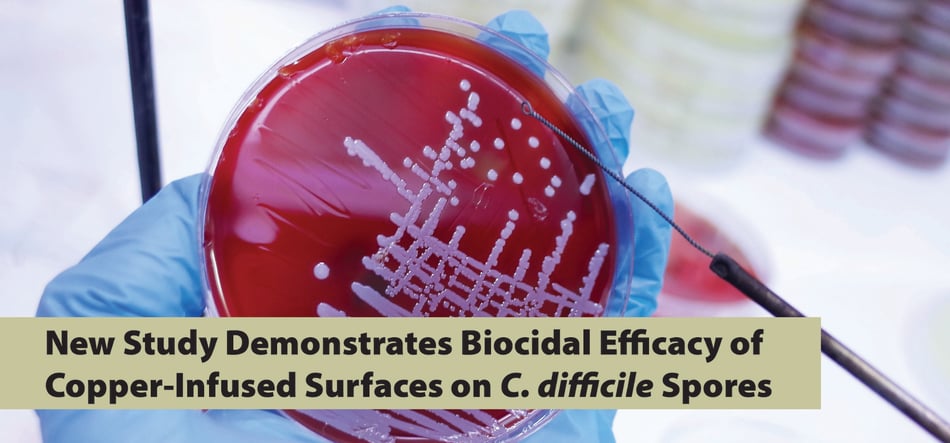

New Study Demonstrates Biocidal Efficacy of Copper-Infused Surfaces on C. difficile Spores
Healthcare-associated infections (HAIs) remain a significant challenge in clinical environments, and Clostridioides difficile (C. difficile) is one of the most persistent culprits. As a spore-forming bacterium, C. difficile poses unique challenges for infection prevention due to the resilience of its spores compared to its vegetative cells. A recent study represents a major advancement in combating this pathogen: copper-impregnated surfaces have been shown to significantly reduce C. difficile spore contamination.
Key Findings of the Study
This groundbreaking study, conducted by researchers at the Central Texas Veterans Health Care System and Texas A&M University, is the first to design and employ a protocol specifically designed to test the efficacy of biocidal surfaces against C. difficile spores, not just easier-to-kill vegetative cells. This publication represents one in a series of studies funded by a National Institutes of Health R01 grant, which fund programs that have national public health implications. (For key points from the investigators, see this article.) The findings highlight the potential for copper surfaces to reshape infection control strategies in healthcare settings:
-
Efficacy Against C. difficile Spores
-
Copper-impregnated EOSCU demonstrated a significant reduction in spore burden compared to control solid surface and stainless steel. During the 4-hour wait time, spores were reduced by 97% on clean surfaces, and by 92% on soiled surfaces (organic material to simulate a real-world spill event).
-
Spores, unlike vegetative bacteria, are highly resistant to environmental stressors and disinfectants. The study’s results confirm copper’s ability to disrupt spore viability, a critical factor in controlling C. difficile transmission.
-
-
Innovative Testing Protocol
-
This study marks the first time a standardized protocol was designed and used to test the effects of a biocidal surface specifically against C. difficile spores. Previous research primarily focused on vegetative bacteria, which are far easier to kill and easier to work with in a lab environment. However, spores are highly prevalent in the real-world environment. By addressing spores, the study provides a more realistic assessment of copper’s potential in real-world healthcare environments.
-
-
Continuous Protection
-
Copper surfaces offer round-the-clock antimicrobial activity, actively reducing environmental contamination between cleaning cycles. This continuous efficacy provides an additional safeguard in high-touch areas, such as bed rails, overbed tables, and nurse stations.
-
Why Target C. difficile Spores?
C. difficile spores are particularly problematic because they can persist on surfaces for extended periods, surviving routine cleaning and disinfecting protocols for weeks, months, and even years. When patients or healthcare workers come into contact with these contaminated surfaces, the risk of infection transmission increases. Unlike vegetative cells, spores require targeted measures for effective eradication, making this study’s focus on spore reduction a critical step forward.
How Do Copper Surfaces Work?
Copper’s biocidal properties stem from its ability to release ions that penetrate microbial cells and disrupt key processes, including respiration and DNA synthesis. When it comes to spores, copper ions likely interfere with the integrity of the spore coat and inner membrane, rendering them nonviable. This unique mechanism enables copper to tackle even the hardiest pathogens, including C. difficile.
Implications for Infection Prevention
The study’s findings have significant implications for healthcare facilities striving to reduce HAIs:
-
Enhanced Environmental Hygiene: Incorporating copper-impregnated materials into high-touch areas can reduce environmental reservoirs of C. difficile, complementing traditional cleaning protocols.
-
Spore-Specific Efficacy: By targeting spores, copper surfaces address a critical gap in current infection prevention strategies.
-
Evidence-Based Solutions: This study provides a robust, scientifically validated foundation for the adoption of copper-infused surfaces in healthcare settings.
A Paradigm Shift in Surface Materials
This research underscores the need for healthcare facilities to prioritize surfaces that actively contribute to infection prevention. Traditional materials, while durable and easy to clean, do little to mitigate microbial contamination. Copper-infused surfaces, by contrast, are not only durable and easy to clean, they also represent a proactive approach to reducing the bioburden in patient environments.
The use of copper-impregnated surfaces offers a novel and effective solution to one of healthcare’s most persistent challenges: the transmission of C. difficile spores. By employing a first-of-its-kind testing protocol, this study provides compelling evidence of copper’s potential to enhance patient safety and reduce HAIs. As healthcare facilities continue to prioritize infection prevention, adopting innovative materials like copper may prove indispensable in creating safer environments for patients and staff alike.
![EOScu Logo - Dark - Outlined [07182023]-01](https://blog.eoscu.com/hubfs/Eoscu_June2024/Images/EOScu%20Logo%20-%20Dark%20-%20Outlined%20%5B07182023%5D-01.svg)




